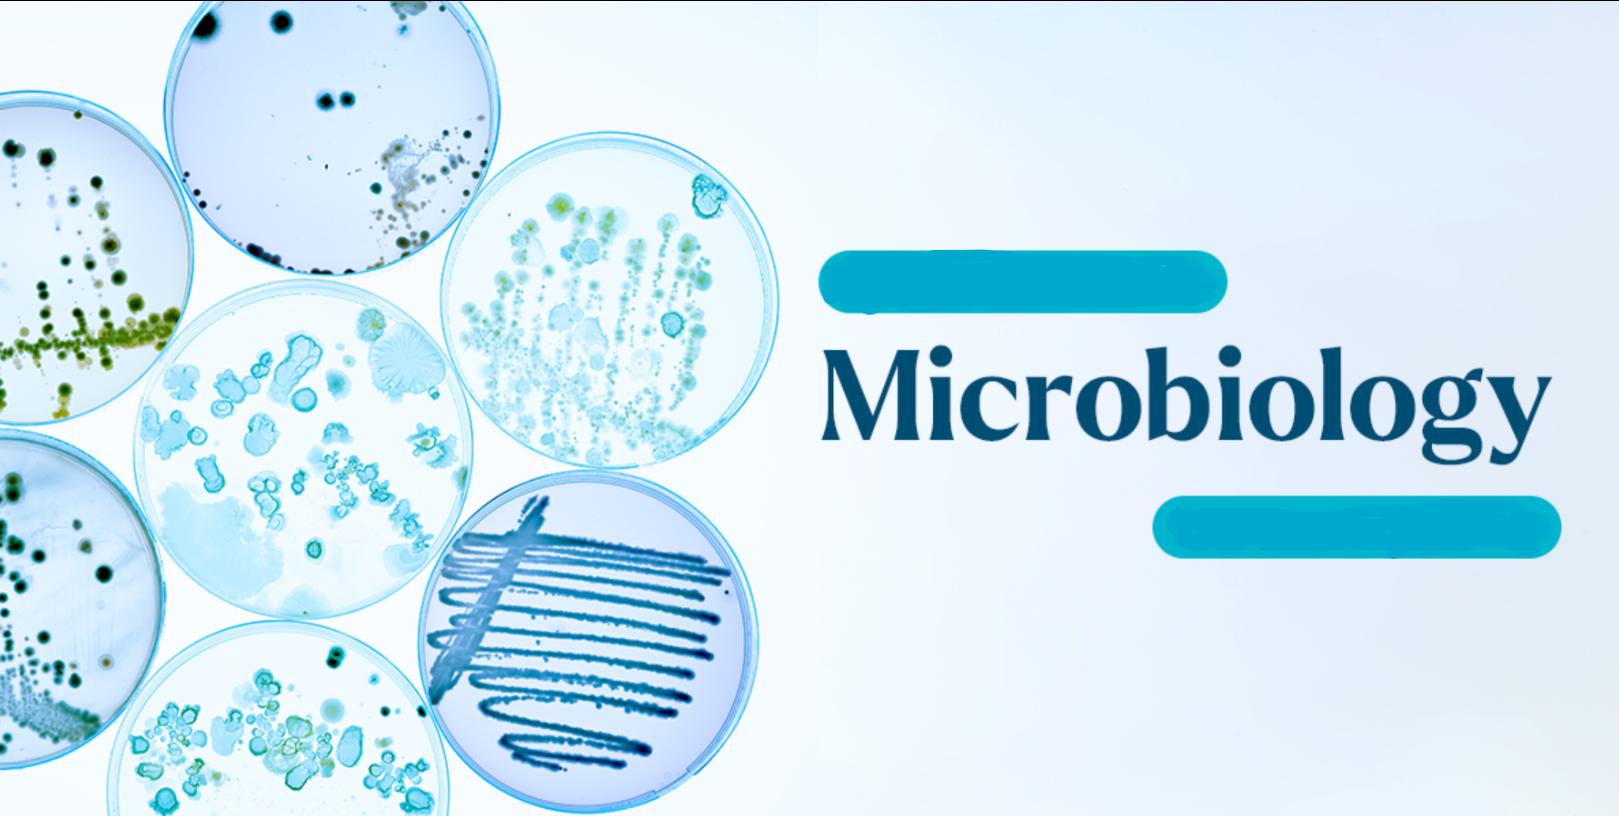

Microbiology is the branch of science that deals with microscopic organisms and their interaction with other microscopic and macroscopic organisms. It deals with the structure, function, classification of such organisms, along with exploiting and controlling their activities.
Microorganisms are tiny microscopic organisms that are too small to be seen with naked eyes and thus, can only be seen with a microscope. Microorganisms include microscopic organisms like bacteria, fungi, archaea, protozoa, and viruses.
- Enseignant: Khadidja Fellah